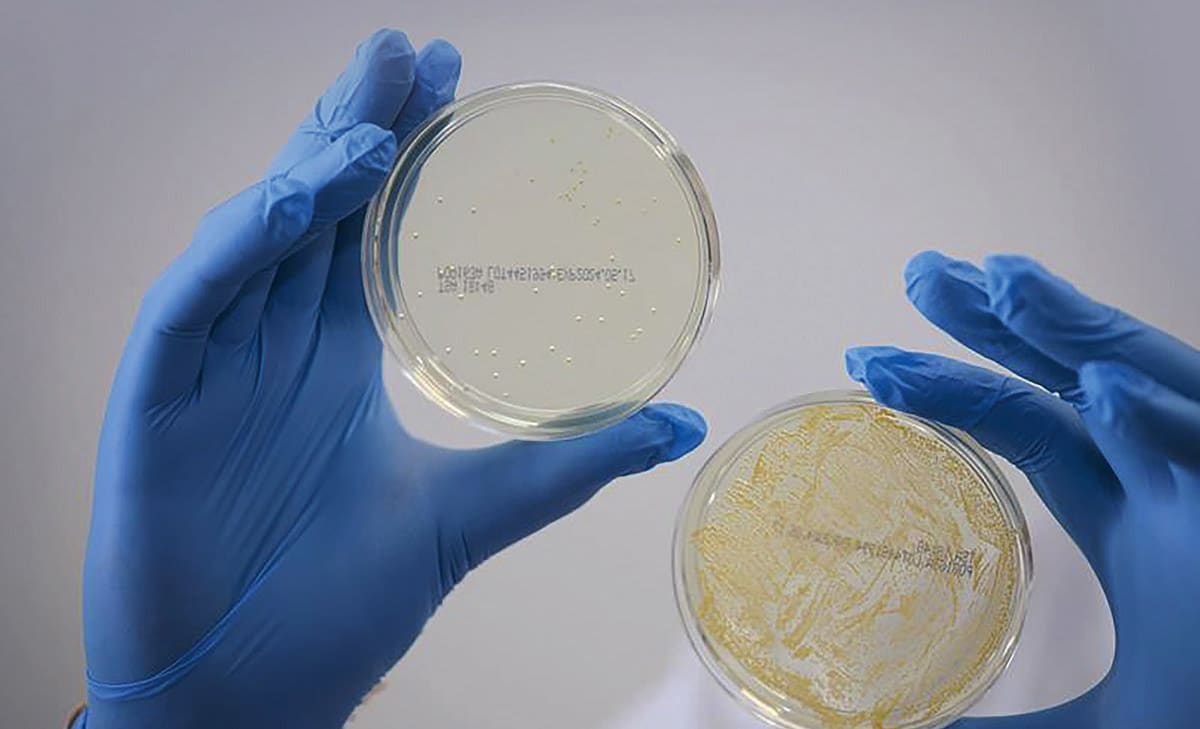

Image credit: BioInteractions
As many as 60 percent of the growing number of healthcare-associated infections (HAIs) are associated with surgically implanted medical devices, which has significant implications for morbidity and healthcare costs.
Implants are prone to device-related infections and, according to a 2022 MDPI review, passive sanitization often fails to stop biofilm from building up, making self disinfecting surface solutions crucial. 1
Furthermore, implanted devices often need to be replaced or reinserted, which increases the risk of infection and means the patient needs extensive drug regimens.
In answer to this increasing issue, an emerging generation of protective active surface coatings, called surface-active systems, has been designed to tackle this issue. While the category is still relatively little-known among clinicians, it is creating growing interest.
Implant-related infection has direct impacts on patient outcomes, according to Nicholas Inston, president-elect of the Vascular Access Society and consultant surgeon in Vascular Access and Transplantation at Queen Elizabeth Hospital, Birmingham, UK.
“Catheters have long been viewed as a temporary or highrisk solution, but for many patients they are the only or preferred form of access,” he says.
But catheter use has become far more viable with the introduction of advanced permanently effective, zero-leaching coatings, such as BioInteractions’ coating technologies. They reduce complications, make the device function better, and improve outcomes, making catheters a safer option.
Safeguarding all surfaces in healthcare — including implantable devices — is increasingly critical to the infection prevention infrastructure across hospitals, clinics, and longterm care.
Modern antimicrobial coatings improve safety and health outcomes by reducing device-related and surgical site infections, and enhancing the longevity of the implanted device.
This new generation of antimicrobial coatings can also inhibit microbial colonization, helping prevent bloodstream infections before they start, reducing complications, making implantations safer and reducing the need for costly interventions such as device replacement or antibiotics.
Infection is just one of the challenges for healthcare professionals. These new coatings can also be engineered to reduce clotting or to make implant insertion easier and safer. Devices like total artificial hearts (TAHs), ventricular assist devices (VADs), vascular stents, and prosthetic mechanical heart valves face the common challenge of lifetime hemocompatibility, specifically thrombosis, and occlusion of surfaces.
Additionally, the development of miniaturized and minimally invasive procedures presents the problem of friction caused during the insertion and removal of the devices — which in turn can cause tissue trauma. Addressing this issue can lead to improved surgical outcomes, less pain and faster recovery.
The evolution in medical coatings means they are no longer just additional features — passive barriers that simply sit on the surface of a device — but rather essential agents of protection fundamental to the device’s performance.
The coatings, which can be tailored to individual clinician requirements, represent a holistic rethinking of how implants interact with the human body. As this technology matures, it has the potential to reduce dependence on systemic drugs, particularly in high-risk patients who might otherwise face the burden of long-term therapy.
This exciting and transformative area of product research and development has created a range of safe, high-performance, and biocompatible hydrophilic, antimicrobial, and antithrombogenic coating solutions.
Surface-active systems comprises a variety of coating options, each offering specific benefits for particular uses. Collectively they are designed to improve implant performance, enhance patient safety and evolve the therapeutic benefits for a better quality of life.
They aim to minimize immune response, resist degradation, and maintain function in the body’s most complex and tortuous environments. By preventing infection or reducing clot formation at the device surface, these coatings address two of the most serious risks associated with implants: bloodstream infections and thrombosis.
Long-lasting, site-specific antimicrobial or thromboresistant protection — without the need for systemic drugs — has the potential to transform how vascular access is managed.
This technology means that implants are safer, perform better and last longer. Meanwhile, patient outcomes can be fundamentally transformed: patients recover more quickly, have less need for additional surgeries or treatments, and can have an enhanced quality of life after surgery.
“By reducing the need for systemic antibiotics, minimizing interventions, preventing thrombin sheath development, and lowering hospital readmissions, these coatings could help reshape clinical strategies, ease the burden on healthcare systems, and give patients greater safety and control over their care,” says Inston.
All of the coatings in the category are suitable for a wide variety of medical component geometries, ranging from tiny metal implants of less than 5 μm to larger polymer-based systems of more than 20 m.
The technology provides protection on all kinds of substrates, including soft materials like silicone and fabrics, hard materials like metals, and polymers.
From the device manufacturer’s perspective, these solutions offer clear benefits. Not only are they suitable for a wide variety of medical components, device geometries, and substrates, but devices last longer and work more efficiently and safely.
In addition, the supplier works closely with OEM customers on research, design, testing and regulatory compliance of bespoke coatings, helping them navigate a highly regulated environment.
This focus on regulatory compliance, patient-first design and scientific excellence in turn increases speed to market.
Overall, the goal is to deliver the best in leading-edge, next-generation biomaterials that offer biocompatibility, hemocompatibility, protection against infection, and ease of use.
What Treatments Are in This Category?
There are two main product ranges: Surface-active therapeutics and surface-active materials.
Surface-Active Therapeutics (SATs). These are advanced biocompatible surface coatings applied directly to the surface of medical devices, incorporating both active and passive components to provide permanently effective and non-leaching benefits (e.g., antimicrobial or antithrombogenic).
They ensure enhanced properties are applied onto a device surface, which range from reducing infections and biofilms (a key source of implant-related infections) to other clinical issues such as thrombosis and fibrin sheath formation. In turn, this means better performing devices with fewer complications, quicker recoveries, and safer interventions.
Unlike traditional drug-based solutions, these durable, polymer-based barriers remain active on the device surface throughout the device’s lifetime. Instead of releasing active ingredients, they form a continuous durable barrier on the device surface.
These SATs are proven to provide fast acting, long lasting, and durable properties without systemic risks to the patient. These technologies provide advantages from patient, to physician as well as to the healthcare provider. Utilizing SATs delivers advanced benefits which improves device performance, enhances patient safety, and provides therapeutic benefits. This results in better interventions, faster recovery, and improved lifestyle and well-being.
SATs can be applied onto a wide range of medical devices with vastly varying geometries and substrates. These include soft materials such as woven and non-woven fabrics, as well hard surfaces such as metals and polymers as well as all those in between these broad categories.
One such SAT is BioInteractions’ TridAnt®, a one-step, one-layer antimicrobial shield that is permanently effective against a wide range of pathogens for the patient’s lifetime. It utilizes a contact kill mechanism to instantly kill a full spectrum of pathogens, including bacteria (including drug resistant strains), fungi and yeast. These include E. coli, MRSA, Pseudomonas aeruginosa, and Candida albicans. Additionally, it combats bacterial colonization and protein deposition, acting as a localized, sustained, protective shield and can disrupt and prevent biofilm growth.
Safe for use anywhere in the body, this zero-leaching innovation has a wide variety of clinical applications, from orthopedic implants to urinary devices, and from vascular access devices, to respiratory devices.
It enhances the safety and functionality of medical devices, improving protection and reducing infections, meaning quicker recoveries and fewer complications, and minimizing the need for additional surgeries and longterm antibiotics.
Coated surfaces function as a tool for combating infection for as long as they remain in the body, thanks to technology called Contact 2 Contact Kill. Unlike conventional coatings that release their active components and ultimately wear down, therefore becoming less efficient over time, TridAnt is engineered to offer lifelong antimicrobial protection in the most stressful and tortuous applications.
AstutePlus®, another technology in the SAT range, is a one-layer, one-step advanced antithrombogenic coating that addresses the considerable risks associated with blood-contacting implants: thrombus, fibrin sheath, and other forms of occlusion.
Its active components protect implanted devices by halting the blood cascade mechanism and preventing platelets from activating. This is combined with passive elements preventing blood components and proteins from depositing and adhering to the device surface.
A single long-lasting, biocompatible layer prevents platelet activation and resists adhesion, so protecting devices against thrombosis and fibrin sheath formation.
This antithrombogenic protection lasts for the lifetime of the patient, enhancing the safety and functionality of devices like heart valves, stents, and central venous catheters (CVCs). It enhances the safety and effectiveness of treatments like hemodialysis, so reducing the need for additional surgeries, continuing interventions and long-term medication. The zero-leaching, permanently effective coating has been successfully used on blood-contacting medical implants for more than 25 years.
Both AstutePlus and TridAnt withstand sterilization, are compliant with medical device related regulatory processes (including MDR), and have been tested to ISO biocompatibility standards.
Surface-Active Materials (SAMs). SAMs are high-performance and highly durable technologies that provide long-lasting passive properties to a device surface. An example would be hydrophilic surface treatments that make it easier to implant or remove devices even in highly tortuous applications.
The objective of SAMs are to provide surface solutions that utilize passive properties to significantly enhance the device surface. These include durable-hydrophilic technologies to antifouling technologies. There are a range of surface requirements throughout the medical device industry that require additional properties that are not found with active pharmaceuticals. SAMs are positioned to provide a range of solutions that confront these specific challenges.
BioInteractions’ Assist™ is a one-layer, one-step durable and flexible hydrophilic surface treatment in this range, engineered to drastically reduce friction on device surfaces without forming particulates and delaminating in high-stress and tortuous applications.
The technology can be applied onto surfaces that expand and contract significantly without hindering the device performance. It continues to improve the laminar flow of liquids when applied on the internal surfaces therefore providing adhesion to support the flow of liquids. It is also well utilized in tough environments where devices are subjected to friction, expansion, and movement. Uses include central venous catheters, joint devices and feeding tubes.
This type of surface treatment is flexible and durable in order to minimize tissue damage, meaning patients are more comfortable during the procedure which supports better recovery times, and the devices work better and more consistently over time and in high stress and tortuous environments.
Assist is instantly activated through wetting so the surface does not need to be presoaked. This makes device deployment quicker and more straightforward. The Assist technology has been used for over 25 years on FDA-approved and CE-approved medical devices without any rejection or recall. It has been tested to ISO biocompatibility standards.
All these advanced protective surface treatments (SATs and SAMs) offer interesting and appealing solutions for a new world of medical devices for manufacturers.
Reference
- Pamela M. Lundin, et al., “Functionalized Self-Assembled Monolayers: Versatile Strategies to Combat Bacterial Biofilm Formation,” Pharmaceutics 2022, 14 (8), 1613.
This article was written by Arjun Luthra, Commercial Director for BioInteractions, Reading, UK. For more information, visit here .

